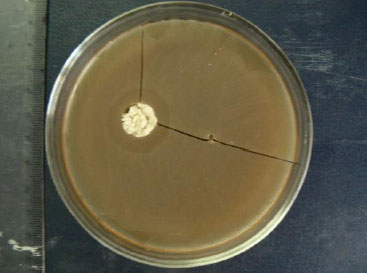
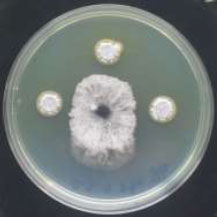
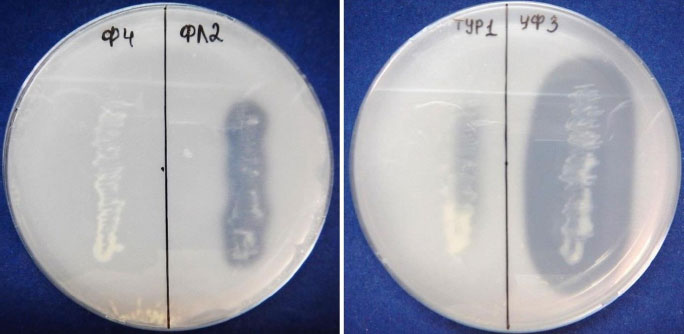

Special Issue 1: Durable genetic plant resistance: A key to sustainable pathogen management
Edited by: Nachaat Sakr
December 30, 2022
Tamara K. Ternovska, Tetiana S. Iefimenko and Maksym Z. Antonyuk
Natalia Kozub, Oksana Sozinova, Igor Sozinov, Anatolii Karelov, Liliya Janse, Lidiya Mishchenko, Oleksandr Borzykh and Yaroslav Blume
Manas Kumar Bag, Shivappa Raghu, Amrita Banerjee, Seenichamy R. Prabhukarthikeyan, Mathew S. Baite and Manoj Yadav